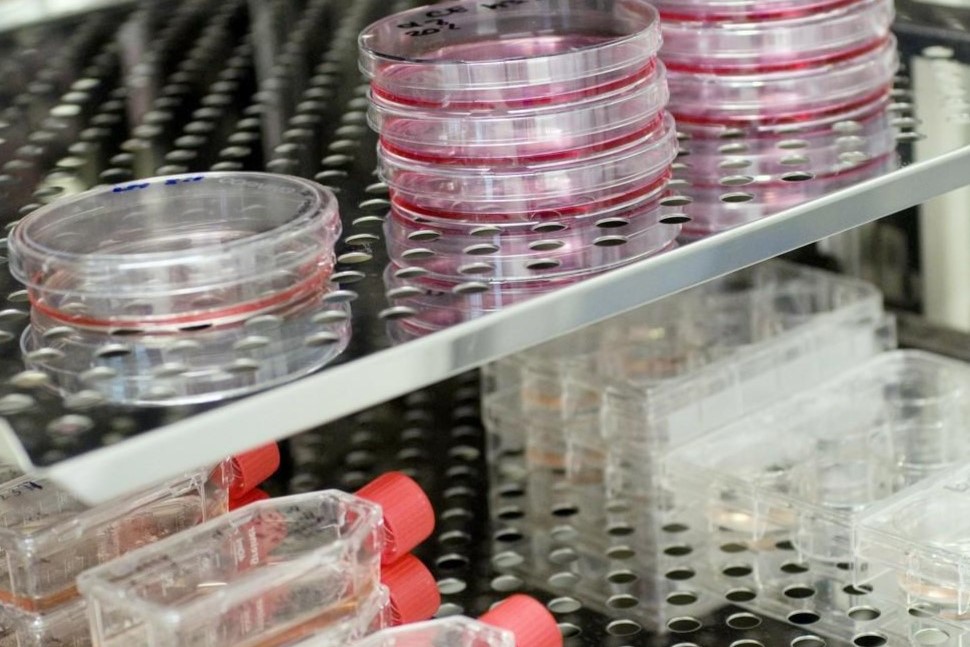

TECHNOLOGY PLATFORM
技术平台
技术服务
产业转化
NEWS CENTER
新闻中心
-
尊敬的合作伙伴、行业同仁及社会各界: 浙江华槃生物技术有限公司(Zhejiang HOPREN Bioscience Co., Ltd.)谨此宣布:浙江华槃生物技术有限公司高新技术研究中心下属的华槃病原微生物实验室(加强型BSL-2)正式通过杭州市疾控中心等相关部门审核,成功取得国家生物安全实验室(加强型BSL-2)备案证书。拟开展慢病毒、新冠病毒、高致病性禽流感病毒、呼吸合胞病毒、流行性感冒病毒、肺炎支原体、脑膜炎奈瑟氏球菌等多种病原体的相关研究。这标志着华槃生物的实验室建设与管理水平迈上了新的台阶,为公司深入开展病原微生物相关研究奠定了坚实的安全基础。 自新基地启动建设以来,华槃生物严格遵循《中华人民共和国生物安全法》及《实验室生物安全通用要求》等国家标准,对实验室进行了全方位升级与优化。在备案申请过程中,公司系统完善了生物安全管理体系文件,并对实验人员进行了多轮专业培训与考核,最终顺利完成国家生物安全实验室(加强型BSL-2)备案。 此次备案的成功通过,不仅是对华槃生物生物安全防护能...
-
为深入强化实验室生物安全风险管控能力,进一步提升专业技术人员的生物安全素养,3月20日-22日,浙江华槃生物技术有限公司高新技术研究中心派员参加了由浙江省医学科技教育发展中心联合杭州市疾病预防控制中心举办的省级实验室生物安全人员培训,并通过考核。 本次培训聚焦生物安全法律法规、风险识别与管控、实验活动规范化操作等内容。通过此次系统学习,不仅有效提升了我司人员对生物安全风险的防范意识,也为公司进一步完善BSL-2生物安全实验室管理体系、确保各项工作规范有序开展奠定了坚实基础。
-
近日,江西某三甲医院神经外科成功为一名12岁颅脑外伤患儿实施自体颅骨修补术。作为此次手术的关键支撑环节,华槃集团旗下专业骨库承担了患儿自体颅骨的标准化处理与深低温保存工作,通过全流程规范化管理,确保了这块珍贵自体骨瓣在三个月后完好、无菌地回归患儿体内,助力手术圆满成功[1]。 紧急施救,为患儿长远健康谋划最佳方案 2025年9月,一名12岁患儿因外伤导致意识障碍,被紧急送往急诊就诊,经检查确诊为“脑疝”,病情危急。主任第一时间启动紧急预案,当日成功为其施行颅骨去骨瓣减压术+颅内血肿清除术+颅压探极置入术,清除了颅内血肿,有效降低了颅内压力,挽救了患儿的生命。 【图片可能引起不适,请谨慎查看】 术后,经神经外科医护团队精心治疗与护理,患儿病情平稳出院,医嘱预约三个月后返院完成颅骨修补。 突破壁垒,为患儿长远健康选择最优方案 面对年仅12岁、正处于生长发育关键阶段的患儿,为最大限度保障未来颅骨生长匹配与组织相容性,主任毅然决定摒弃常规人工材料修补路径,坚持采用自体颅骨回植这一对儿童更优的技术方案。...
-
尊敬的公益伙伴、全体员工及社会各界爱心人士: 浙江华槃生物技术有限公司(Zhejiang HOPREN Bioscience Co., Ltd.)谨此宣告:2025年8月29日至8月31日,公司与杭州市临平区康乃馨儿童学校(自闭症儿童教育机构)联合开展的“星光重生,六角织梦”公益活动圆满落幕。 华槃生物向该校捐赠“六角恐龙生态系统”,组成康乃馨“生物角”的第三部分,旨在通过自然生物疗愈力,为“来自星星的孩子们”开启一扇感知世界、连接情感的新窗口。 此次捐赠不仅是一次生物的馈赠,更是一场关于爱与陪伴的创新实践。当六角恐龙如羽如纱的六角鳃在水中轻轻摇曳,当孔雀鱼舒展绚烂的尾鳍划出梦幻般的涟漪,这些跃动的生命意象,正以一种安静而神奇的方式,“游”进孩子们的世界深处——它们既是视觉中一片温柔的“蓝色海洋”,更是心灵上一处稳定的“疗愈锚点”,让孩子们在自然的守护中,感知这个世界的柔软与美好。 在教师节来临之际,华槃生物以「乐...
-
尊敬的合作伙伴、行业同仁及社会各界: 浙江华槃生物技术有限公司(Zhejiang HOPREN Bioscience Co., Ltd.)谨此宣布:浙江华槃生物技术有限公司高新技术研究中心下属的华槃病原微生物实验室(加强型BSL-2)正式通过杭州市疾控中心等相关部门审核,成功取得国家生物安全实验室(加强型BSL-2)备案证书。拟开展慢病毒、新冠病毒、高致病性禽流感病毒、呼吸合胞病毒、流行性感冒病毒、肺炎支原体、脑膜炎奈瑟氏球菌等多种病原体的相关研究。这标志着华槃生物的实验室建设与管理水平迈上了新的台阶,为公司深入开展病原微生物相关研究奠定了坚实的安全基础。 自新基地启动建设以来,华槃生物严格遵循《中华人民共和国生物安全法》及《实验室生物安全通用要求》等国家标准,对实验室进行了全方位升级与优化。在备案申请过程中,公司系统完善了生物安全管理体系文件,并对实验人员进行了多轮专业培训与考核,最终顺利完成国家生物安全实验室(加强型BSL-2)备案。 此次备案的成功通过,不仅是对华槃生物生物安全防护能...
-
为深入强化实验室生物安全风险管控能力,进一步提升专业技术人员的生物安全素养,3月20日-22日,浙江华槃生物技术有限公司高新技术研究中心派员参加了由浙江省医学科技教育发展中心联合杭州市疾病预防控制中心举办的省级实验室生物安全人员培训,并通过考核。 本次培训聚焦生物安全法律法规、风险识别与管控、实验活动规范化操作等内容。通过此次系统学习,不仅有效提升了我司人员对生物安全风险的防范意识,也为公司进一步完善BSL-2生物安全实验室管理体系、确保各项工作规范有序开展奠定了坚实基础。
-
近日,江西某三甲医院神经外科成功为一名12岁颅脑外伤患儿实施自体颅骨修补术。作为此次手术的关键支撑环节,华槃集团旗下专业骨库承担了患儿自体颅骨的标准化处理与深低温保存工作,通过全流程规范化管理,确保了这块珍贵自体骨瓣在三个月后完好、无菌地回归患儿体内,助力手术圆满成功[1]。 紧急施救,为患儿长远健康谋划最佳方案 2025年9月,一名12岁患儿因外伤导致意识障碍,被紧急送往急诊就诊,经检查确诊为“脑疝”,病情危急。主任第一时间启动紧急预案,当日成功为其施行颅骨去骨瓣减压术+颅内血肿清除术+颅压探极置入术,清除了颅内血肿,有效降低了颅内压力,挽救了患儿的生命。 【图片可能引起不适,请谨慎查看】 术后,经神经外科医护团队精心治疗与护理,患儿病情平稳出院,医嘱预约三个月后返院完成颅骨修补。 突破壁垒,为患儿长远健康选择最优方案 面对年仅12岁、正处于生长发育关键阶段的患儿,为最大限度保障未来颅骨生长匹配与组织相容性,主任毅然决定摒弃常规人工材料修补路径,坚持采用自体颅骨回植这一对儿童更优的技术方案。...
-
尊敬的公益伙伴、全体员工及社会各界爱心人士: 浙江华槃生物技术有限公司(Zhejiang HOPREN Bioscience Co., Ltd.)谨此宣告:2025年8月29日至8月31日,公司与杭州市临平区康乃馨儿童学校(自闭症儿童教育机构)联合开展的“星光重生,六角织梦”公益活动圆满落幕。 华槃生物向该校捐赠“六角恐龙生态系统”,组成康乃馨“生物角”的第三部分,旨在通过自然生物疗愈力,为“来自星星的孩子们”开启一扇感知世界、连接情感的新窗口。 此次捐赠不仅是一次生物的馈赠,更是一场关于爱与陪伴的创新实践。当六角恐龙如羽如纱的六角鳃在水中轻轻摇曳,当孔雀鱼舒展绚烂的尾鳍划出梦幻般的涟漪,这些跃动的生命意象,正以一种安静而神奇的方式,“游”进孩子们的世界深处——它们既是视觉中一片温柔的“蓝色海洋”,更是心灵上一处稳定的“疗愈锚点”,让孩子们在自然的守护中,感知这个世界的柔软与美好。 在教师节来临之际,华槃生物以「乐...